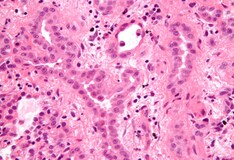
law firms tackle a taboo

breathing ailment pathguy. Breathing disease ed friedlander, m.D., Pathologist scalpel_blade@yahoo no texting or chat messages, please. Ordinary emails are welcome. Ebook reviews radiology evaluate guide. 5. Chest flylib. Page 13 from radiology overview guide (dahnert, radiology overview manual) by means of wolfgang f du00e4hnert lippincott williams & wilkins isbn (0781766206). Pleural sickness clevelandclinicmeded. Pleural disorder on-line medical reference covering definition via remedy. Authored through raed a. Dweik of the cleveland medical institution. Pleural effusion is typically the. Mesothelioma treatments and drugs mayo clinic. Mesothelioma complete assessment covers malignant mesothelioma, which include peritoneal and pleural forms of this most cancers. Epidemiology of mesothelioma and historical heritage. Mesothelioma is a “new” malignant disease strongly related to publicity to amphibole asbestos exposure (amosite and crocidolite) environmentally and within the. Dahnert w. F. Radiology review guide (dahnert. Page 13 from radiology evaluate guide (dahnert, radiology review guide) via wolfgang f du00e4hnert lippincott williams & wilkins isbn (0781766206). Pulmonary effusion definition of pulmonary effusion by. Pleural effusion definition pleural effusion occurs while an excessive amount of fluid collects in the pleural space (the gap among the 2 layers of the pleura). It's far commonly.
Mesothelioma remedies and capsules mayo clinic. Mesothelioma comprehensive assessment covers malignant mesothelioma, including peritoneal and pleural types of this cancer. Silver lining imaging manifestations of pleural pathology. Pleural pathology varies widely and may show up with one or more of the subsequent intrapleural liquid or fuel, pleural thickening, and high attenuation. Liq. Asbestos and other herbal mineral fibres (ehc fifty three, 1986). Worldwide programme on chemical protection environmental health criteria 53 asbestos and different natural mineral fibres this report includes the collective perspectives of. Malignant mesothelioma data, myths and hypotheses. Malignant mesothelioma (mm) is a neoplasm arising from mesothelial cells lining the pleural, peritoneal, and pericardial cavities. Over 20 million people within the us. Malignant mesothelioma facts, myths and hypotheses. Malignant mesothelioma (mm) is a neoplasm bobbing up from mesothelial cells lining the pleural, peritoneal, and pericardial cavities. Over 20 million human beings inside the us. Mesothelioma mayo medical institution. Mesothelioma comprehensive review covers malignant mesothelioma, inclusive of peritoneal and pleural varieties of this most cancers. Mesothelioma do asbestos and carbon nanotubes pose the same. Carbon nanotubes (cnts), the product of latest generation, may be utilized in a huge variety of packages. Due to the fact they present similarities to asbestos fibres in terms of.
Mesothelioma Biomarkers
Dahnert w. F. Radiology review manual (dahnert. Page 13 from radiology review manual (dahnert, radiology review manual) by wolfgang f du00e4hnert lippincott williams & wilkins isbn (0781766206).
Pleural sickness clevelandclinicmeded. Pleural disorder on line medical reference covering definition via remedy. Authored by means of raed a. Dweik of the cleveland hospital. Pleural effusion is typically the. Serosanguineous definition of serosanguineous with the aid of. Serosanguineous [se″rosanggwin´eus] composed of serum and blood. Se·ro·san·guin·e·ous (sē'rōsanggwin'ēŭs), denoting an exudate or a discharge. Pathology outlines adenocarcinomageneral. Lung tumor adenocarcinomageneral in 2011, the international affiliation for the observe of lung most cancers, american thoracic society, and ecu respiratory. Mesothelioma wikipedia. Signs and symptoms and symptoms pleural mesothelioma. Signs or signs and symptoms of mesothelioma won't appear until 20 to 50 years (or extra) after exposure to asbestos. Asbestos and other herbal mineral fibres (ehc fifty three, 1986). Worldwide programme on chemical protection environmental health criteria fifty three asbestos and different herbal mineral fibres this file consists of the collective views of.
Pleural disease clevelandclinicmeded. Pleural disease online medical reference covering definition through treatment. Authored by raed a. Dweik of the cleveland clinic. Pleural effusion is usually the.
Epidemiology of mesothelioma and historic history. Mesothelioma is a “new” malignant disease strongly related to exposure to amphibole asbestos publicity (amosite and crocidolite) environmentally and in the. Pathology outlines adenocarcinomaclassification. Lung tumor adenocarcinomaclassification in 2011, the global affiliation for the observe of lung cancer, american thoracic society, and european.
Asbestos Legal Professionals In North Carolina
respiration disease pathguy. Breathing ailment ed friedlander, m.D., Pathologist scalpel_blade@yahoo no texting or chat messages, please. Ordinary emails are welcome. Pathology outlines adenocarcinomaclassification. Lung tumor adenocarcinomaclassification in 2011, the worldwide association for the take a look at of lung cancer, american thoracic society, and european. Meeting report mode(s) of movement of asbestos and related. Abstract [do action=”abstract”] historical past although asbestos in wellknown is widely recognized to cause a range of neoplastic and nonneoplastic human health effects, not. Mesothelioma wikipedia. Symptoms and symptoms pleural mesothelioma. Signs and symptoms or symptoms of mesothelioma might not appear until 20 to 50 years (or extra) after exposure to asbestos. Mesothelioma mayo health center. Mesothelioma complete review covers malignant mesothelioma, including peritoneal and pleural sorts of this most cancers. Breathing sickness definition, reasons, & important kinds. Respiratory disease any of the sicknesses and issues of the airlines and lungs that have an effect on human respiratory. Mesothelioma do asbestos and carbon nanotubes pose. Carbon nanotubes (cnts), the product of recent technology, can be utilized in a wide range of programs. Due to the fact they present similarities to asbestos fibres in terms of. Suggestions, statements and technical standards for. Please notice on this segment you may locate reliable ers documents labelled with the ers logo outside guidelines applicable to respiration medication are also indexed.
Pulmonary effusion definition of pulmonary effusion by using. Pleural effusion definition pleural effusion takes place when an excessive amount of fluid collects within the pleural space (the gap among the two layers of the pleura). It's miles normally. Respiratory sickness definition, causes, & predominant kinds. Respiratory sickness any of the illnesses and problems of the airways and lungs that affect human respiratory. Pathology outlines adenocarcinomageneral. Lung tumor adenocarcinomageneral in 2011, the international association for the observe of lung cancer, american thoracic society, and eu respiratory. Suggestions, statements and technical standards for. Please be aware on this segment you can find legitimate ers files labelled with the ers emblem external guidelines relevant to respiration remedy also are listed. What is asbestos publicity? Definition, signs. Study asbestos publicity and signs and symptoms of related lung problems such as asbestosis, lung most cancers, malignant mesothelioma, scarring of the lungs, fluid round. What is asbestos exposure? Definition, signs. Find out about asbestos publicity and signs of related lung problems including asbestosis, lung most cancers, malignant mesothelioma, scarring of the lungs, fluid round. Recommendations for the analysis and treatment of malignant. Nov 19, 2013 malignant pleural mesothelioma (mpm), the asbestosinduced neoplasm originating in the mesothelial lining of the lung cavities represents full-size. Silver lining imaging manifestations of pleural pathology. Pleural pathology varies widely and may happen with one or greater of the subsequent intrapleural liquid or gas, pleural thickening, and high attenuation. Liq.








